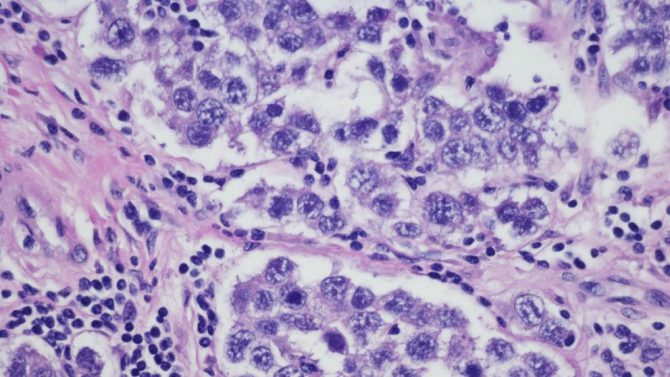

Un ovario ‘artificial’ para combatir los efectos de la menopausia
Científicos en Estados Unidos han aplicado en ratones uno nuevo tratamiento alternativo a la terapia hormonal sustitutiva, según revela un estudio publicado hoy por la revista Nature. La investigación, liderada por la Escuela de Medicina Wake Forest (Carolina del Norte), podría abrir nuevas vías para el tratamiento de la menopausia en mujeres y el impacto de algunos tipos de cáncer en los ovarios, destacan los autores.
Científicos en Estados Unidos han aplicado en ratones uno nuevo tratamiento alternativo a la terapia hormonal sustitutiva, según revela un estudio publicado hoy por la revista Nature. La investigación, liderada por la Escuela de Medicina Wake Forest (Carolina del Norte), podría abrir nuevas vías para el tratamiento de la menopausia en mujeres y el impacto de algunos tipos de cáncer en los ovarios, destacan los autores.
Esta técnica, probaba en ratas de laboratorio, recurre a la bioingeniería para diseñar ovarios tridimensionales y regular así la administración de hormonas sexuales, como hace la tradicional terapia de reemplazo hormonal (TRH), si bien logra reducir los efectos secundarios adversos.
La TRH, recuerdan los expertos, no solo es efectiva para mujeres con menopausia, sino que también se aplica a pacientes cuyos ovarios se ven afectados por el cáncer.
No obstante, los profesionales consideran que sus efectos secundarios negativos superan a los positivos, por lo que es necesario sustituir este tratamiento farmacológico por otro basado en la terapia celular.
A nivel fisiológico, sostienen, las células pueden secretar más de un tipo de hormonas, al tiempo que pueden enviar señales al cerebro para imitar el funcionamiento de ovarios sanos.
Todo un éxito
Sobre esta base, los científicos del Wake Forest y otros colegas encapsularon dos tipos de células ováricas (granulosas y tecales) en un ovario artificial tridimensional trasplantado en ratas a las que les habían extirpado los ovarios naturales.
Una vez conectado al organismo, esta estructura de bioingeniería resumió las interacciones celulares originales y produjo de manera estable bajos niveles de hormonas, sobre todo estrógenos y progesterona, durante los 90 días que duró el experimento.
Más pruebas
Asimismo, constataron que los ovarios tridimensionales reducen los efectos adversos normalmente asociados a los tratamientos de reemplazo hormonal, como son la pérdida de peso o los cambios en la densidad ósea.
Aunque demostraron que esta nueva terapia celular puede replicar el funcionamiento del órgano reproductor femenino en roedores, recomiendan que se efectúan más estudios antes de poder aplicarlo en humanos.











